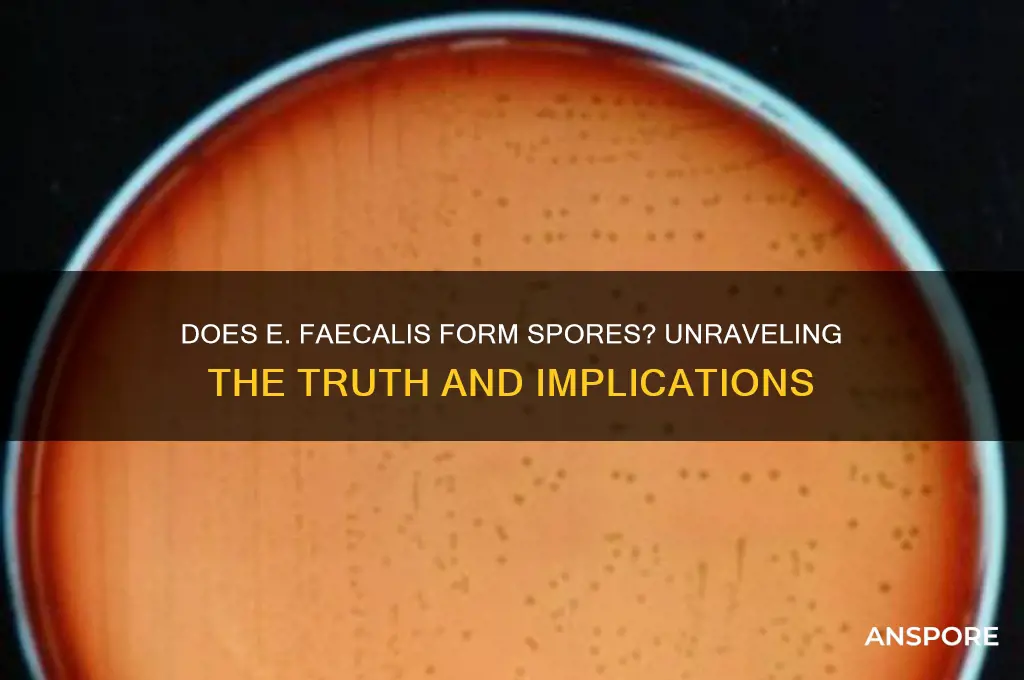
does e faecalis have spores

*Enterococcus faecalis* is a Gram-positive bacterium commonly found in the human gastrointestinal tract and is known for its resilience in various environments. A frequently asked question regarding this bacterium is whether it produces spores, a characteristic that would significantly enhance its survival capabilities. Unlike spore-forming bacteria such as *Clostridium difficile* or *Bacillus anthracis*, *E. faecalis* does not form spores. Instead, its ability to survive harsh conditions, including high salt concentrations, extreme temperatures, and antimicrobial agents, is attributed to its robust cell wall, biofilm formation, and intrinsic resistance mechanisms. Understanding the absence of spore formation in *E. faecalis* is crucial for developing effective strategies to control its spread, particularly in healthcare settings where it is a leading cause of nosocomial infections.
| Characteristics | Values |
|---|---|
| Does E. faecalis have spores? | No |
| Reason | Enterococcus faecalis is a non-spore-forming bacterium. It reproduces through binary fission and does not produce endospores as a survival mechanism. |
| Survival Mechanisms | E. faecalis is highly resilient due to its ability to tolerate harsh conditions, including high salt concentrations, extreme pH levels, and antimicrobial agents, but it does not form spores. |
| Relevance | Its lack of spore formation is important in clinical settings, as it influences its susceptibility to certain sterilization methods and antimicrobial treatments. |
| Taxonomy | E. faecalis belongs to the genus Enterococcus, which is characterized by non-spore-forming, Gram-positive cocci. |
| Clinical Significance | It is a common cause of hospital-acquired infections, particularly in immunocompromised patients, due to its ability to survive in diverse environments without forming spores. |
Explore related products
What You'll Learn

E. faecalis spore formation
Observation: *Enterococcus faecalis* is a resilient bacterium often associated with hospital-acquired infections, yet its survival strategies remain a subject of debate. One critical question is whether it forms spores, a trait that could significantly enhance its environmental persistence. Unlike spore-forming bacteria such as *Clostridium difficile*, *E. faecalis* lacks the genetic machinery for true sporulation. However, it exhibits alternative mechanisms to endure harsh conditions, such as biofilm formation and cellular aggregation, which are sometimes mistaken for spore-like behavior.
Analytical Insight: While *E. faecalis* does not produce spores, its ability to survive desiccation, high temperatures, and antimicrobial agents raises questions about its adaptive strategies. Research suggests that its cell wall composition, particularly the presence of peptidoglycan and lipoteichoic acids, contributes to its robustness. Additionally, its capacity to enter a viable but non-culturable (VBNC) state allows it to evade detection in standard laboratory tests, mimicking the resilience of spore-forming bacteria without actual sporulation.
Instructive Guidance: For healthcare professionals and researchers, distinguishing between true spores and *E. faecalis*'s survival mechanisms is crucial. When disinfecting surfaces or treating infections, use spore-targeted methods (e.g., autoclaving at 121°C for 15–30 minutes) to ensure eradication, as *E. faecalis* can withstand many standard cleaning protocols. However, avoid assuming spore-specific treatments are necessary, as this bacterium’s resistance is not spore-derived but rather linked to its intrinsic cellular structure and biofilm formation.
Comparative Perspective: Compared to spore-forming pathogens like *Bacillus anthracis*, *E. faecalis* relies on biofilms for long-term survival, particularly in hospital environments. Biofilms act as protective matrices, shielding cells from antimicrobials and host immune responses. While spores are dormant, highly resistant structures, *E. faecalis* remains metabolically active within biofilms, enabling it to persist and cause recurrent infections. This distinction highlights the need for biofilm-disrupting agents, such as enzymes or surfactants, in infection control strategies.
Practical Takeaway: Understanding that *E. faecalis* does not form spores but employs alternative survival tactics is essential for effective infection management. Implement multi-pronged approaches, including rigorous disinfection, biofilm disruption, and targeted antimicrobial therapy, to combat this bacterium. For example, combining antibiotics like ampicillin (10–20 mg/kg every 4–6 hours) with biofilm inhibitors can improve treatment outcomes in patients with *E. faecalis* infections. Always consider the bacterium’s unique resilience mechanisms when designing prevention and treatment protocols.
Unveiling the Truth: Are Spores Reproduced Sexually or Asexually?
You may want to see also

Spore-like structures in E. faecalis
Enterococcus faecalis, a resilient bacterium commonly found in the human gut, has long intrigued microbiologists due to its ability to survive harsh conditions. While it is widely accepted that E. faecalis does not form true spores, recent research has uncovered structures that mimic spore-like properties. These structures, often referred to as "spore-like cells," are formed under specific stress conditions, such as nutrient deprivation or exposure to antibiotics. Understanding these formations is crucial, as they may contribute to the bacterium's notorious resistance to eradication, particularly in hospital-acquired infections.
Analyzing these spore-like structures reveals a fascinating survival mechanism. When E. faecalis encounters adverse environments, a small subpopulation of cells undergoes morphological changes, becoming smaller and more dense. These cells exhibit enhanced resistance to heat, desiccation, and antimicrobial agents, much like true spores. However, unlike spores of Bacillus or Clostridium species, these structures lack a thick protein coat and are not as dormant. Instead, they maintain a low metabolic state, allowing them to persist until conditions improve. This distinction is critical for clinicians and researchers, as it influences the strategies used to combat E. faecalis infections.
For healthcare professionals, recognizing the implications of these spore-like structures is essential. Infections caused by E. faecalis, such as endocarditis or urinary tract infections, often require prolonged antibiotic treatment. The presence of these resilient cells can lead to treatment failure or recurrence, as standard antibiotic regimens may not effectively target them. To address this, combination therapies or higher dosages of antibiotics like ampicillin (up to 2g every 4 hours) or vancomycin (15–20 mg/kg every 8–12 hours) may be necessary. Additionally, incorporating antimicrobial stewardship programs can help prevent the emergence of further resistance.
Comparatively, the spore-like structures of E. faecalis differ significantly from those of spore-forming bacteria like Bacillus anthracis. While Bacillus spores are highly dormant and can survive for decades, E. faecalis's spore-like cells remain metabolically active, albeit at a reduced rate. This difference highlights the unique challenges posed by E. faecalis in clinical settings. Unlike true spores, which can be targeted by specific germinants, these structures require a multifaceted approach, combining antibiotics with environmental interventions such as thorough disinfection of medical equipment and surfaces.
In conclusion, while E. faecalis does not produce true spores, its spore-like structures represent a remarkable adaptation to stress. These formations underscore the bacterium's ability to persist in challenging environments, complicating treatment efforts. By understanding their characteristics and limitations, healthcare providers can develop more effective strategies to manage E. faecalis infections. Practical tips include optimizing antibiotic dosages, ensuring rigorous disinfection protocols, and monitoring patients for recurrent infections. This knowledge not only enhances patient care but also contributes to the broader fight against antimicrobial resistance.
Playing Spore Without the Disc: Is It Possible and How?
You may want to see also

E. faecalis survival mechanisms
Enterococcus faecalis, a resilient bacterium commonly found in the human gut, does not form spores. This fact is critical for understanding its survival mechanisms, which rely on alternative strategies to endure harsh conditions. Unlike spore-forming bacteria such as *Clostridium difficile*, *E. faecalis* lacks the ability to produce a dormant, protective spore state. Instead, it thrives through a combination of intrinsic and adaptive traits that enable it to persist in diverse environments, including hospitals, soil, and water.
One of E. faecalis's most notable survival mechanisms is its ability to tolerate extreme conditions, such as high salt concentrations, pH fluctuations, and desiccation. For instance, it can survive on dry surfaces for weeks, a trait that contributes to its prevalence in healthcare-associated infections. This tolerance is partly due to its robust cell wall, which acts as a barrier against environmental stressors. Additionally, *E. faecalis* can enter a VBNC (viable but non-culturable) state under nutrient deprivation, reducing metabolic activity to conserve energy while remaining alive.
Another key survival strategy is biofilm formation. *E. faecalis* produces extracellular polymeric substances (EPS) that allow it to adhere to surfaces and form biofilms, which protect it from antibiotics, host immune responses, and disinfectants. Biofilms are particularly problematic in medical settings, as they can colonize catheters, heart valves, and other implanted devices, leading to persistent infections. Studies show that biofilm-associated *E. faecalis* is up to 1,000 times more resistant to antibiotics like vancomycin compared to planktonic cells.
Metabolic flexibility further enhances *E. faecalis*'s survival. It can utilize a wide range of carbon sources and switch between aerobic and anaerobic respiration, depending on oxygen availability. This adaptability allows it to thrive in the gut, where conditions fluctuate, and in nutrient-poor environments like hospital surfaces. For example, it can metabolize arginine via the arginine deiminase pathway, generating ATP even in the absence of glucose.
Finally, antimicrobial resistance is a critical survival mechanism for *E. faecalis*. It inherently resists many antibiotics, including cephalosporins and aminoglycosides, due to its thick cell wall and efflux pumps. Moreover, it readily acquires resistance genes via horizontal gene transfer, such as those conferring resistance to vancomycin (e.g., *vanA* and *vanB* genes). This makes treating *E. faecalis* infections challenging, often requiring high-dose combinations like ampicillin (2 g every 4 hours) plus ceftriaxone (2 g daily) for severe cases.
In summary, while *E. faecalis* does not form spores, its survival mechanisms—tolerance to stress, biofilm formation, metabolic versatility, and antimicrobial resistance—make it a formidable pathogen. Understanding these strategies is essential for developing effective infection control measures and targeted treatments.
Lycophyta Reproduction: Unveiling the Role of Spores in Their Life Cycle
You may want to see also
Explore related products

Differences between spores and E. faecalis
Observation: *Enterococcus faecalis* is a resilient bacterium often associated with hospital-acquired infections, but it does not form spores. This distinction is crucial for understanding its survival mechanisms compared to spore-forming organisms.
Analytical Insight: Spores are highly resistant, dormant structures produced by certain bacteria, such as *Clostridioides difficile* and *Bacillus anthracis*, to withstand harsh conditions like heat, desiccation, and chemicals. In contrast, *E. faecalis* relies on intrinsic traits like biofilm formation, antibiotic resistance, and tolerance to extreme pH levels for survival. While spores can remain viable for years, *E. faecalis* depends on its ability to persist in hostile environments without entering a dormant state. This difference dictates disinfection strategies—spores require sporicides like bleach or autoclaving at 121°C for 15–30 minutes, whereas *E. faecalis* can often be controlled with standard disinfectants like 70% ethanol or quaternary ammonium compounds.
Instructive Guidance: To differentiate between spore-forming bacteria and *E. faecalis* in a clinical or lab setting, perform a spore stain. Spores appear as bright green dots under a microscope, while *E. faecalis* will stain uniformly. Additionally, culturing at elevated temperatures (e.g., 6.5% NaCl agar at 45°C) can help identify *E. faecalis*, as it thrives under these conditions, unlike most spore-formers. For infection control, ensure surfaces are cleaned with agents effective against both—spore-formers require more aggressive measures, while *E. faecalis* is susceptible to routine disinfection protocols.
Comparative Perspective: While spores are a survival strategy for long-term endurance, *E. faecalis* excels in short-term adaptability. Spores are essentially "time capsules" for genetic material, reactivating when conditions improve. *E. faecalis*, however, actively modifies its environment through biofilm formation, which shields it from antimicrobials and host defenses. This distinction is critical in healthcare—spore-formers like *C. difficile* require isolation and contact precautions, while *E. faecalis* demands rigorous hand hygiene and surface disinfection due to its ability to colonize medical devices and wounds.
Practical Takeaway: Understanding these differences informs targeted interventions. For spore-formers, focus on terminal cleaning with sporicides and proper sterilization of equipment. For *E. faecalis*, prioritize routine disinfection, especially in high-touch areas, and monitor antibiotic use to prevent resistance. While spores demand a "kill" approach, *E. faecalis* requires a "contain and control" strategy, leveraging its inability to form spores as a vulnerability.
Using Spore Creature Creator Creations for Commercial Projects: Legal Insights
You may want to see also

Clinical implications of E. faecalis spores
Enterococcus faecalis, a common inhabitant of the human gut, is notorious for its resilience in clinical settings. While it does not form spores, its ability to survive harsh conditions—such as desiccation, high salt concentrations, and antimicrobial exposure—mimics spore-like tenacity. This survival prowess poses significant challenges in infection control and treatment, particularly in healthcare environments. Understanding its spore-like behavior is critical for clinicians to manage infections effectively and prevent outbreaks.
From an analytical perspective, the absence of true spores in *E. faecalis* means it lacks the genetic machinery for spore formation. However, its robust cell wall and biofilm-forming capabilities enable it to persist on surfaces and medical devices, such as catheters and prosthetics, for weeks. This persistence increases the risk of nosocomial infections, particularly in immunocompromised patients. For instance, biofilm-associated *E. faecalis* infections are notoriously difficult to treat, often requiring prolonged antibiotic regimens. Vancomycin, a common treatment, is typically administered at 15–20 mg/kg every 8–12 hours, but even this may fail due to the bacterium’s intrinsic resistance mechanisms.
Clinicians must adopt a proactive approach to mitigate the risks associated with *E. faecalis*. First, stringent disinfection protocols are essential, as standard cleaning agents may not eliminate the bacterium from surfaces. Hydrogen peroxide-based disinfectants or ultraviolet light treatment are more effective alternatives. Second, early identification of *E. faecalis* in clinical samples is crucial. Molecular diagnostics, such as PCR, can rapidly detect its presence, allowing for timely intervention. Third, combination therapy, such as ampicillin (2 g every 4 hours) plus ceftriaxone (2 g daily), may be necessary to overcome its multidrug resistance, particularly in endocarditis cases.
Comparatively, while *E. faecalis* lacks spores, its clinical implications rival those of spore-forming pathogens like *Clostridioides difficile*. Unlike *C. difficile*, which relies on spores for transmission, *E. faecalis* spreads through direct contact or contaminated equipment. However, both organisms thrive in healthcare settings and require targeted strategies to control. For *E. faecalis*, this includes isolating infected patients, using dedicated equipment, and reinforcing hand hygiene among healthcare workers.
In conclusion, while *E. faecalis* does not produce spores, its spore-like resilience demands a tailored clinical response. By understanding its survival mechanisms and implementing evidence-based practices, healthcare providers can minimize its impact on patient outcomes. Vigilance, early detection, and appropriate treatment remain the cornerstones of managing this persistent pathogen.
Can Flood Spores Wait? Understanding Their Survival and Dormancy Mechanisms
You may want to see also
Frequently asked questions
No, Enterococcus faecalis (E. faecalis) does not produce spores. It is a non-spore-forming bacterium.
Yes, E. faecalis can survive in harsh conditions due to its inherent resistance to environmental stresses, such as high salt concentrations, drying, and certain disinfectants, despite not forming spores.
E. faecalis is sometimes confused with spore-forming bacteria because of its ability to persist in hospital environments and resist disinfection, traits often associated with spore-forming organisms like Clostridium difficile.
While E. faecalis does not form spores, its intrinsic resistance to many antibiotics and disinfectants makes it challenging to treat and eradicate, requiring specific antimicrobial strategies.































